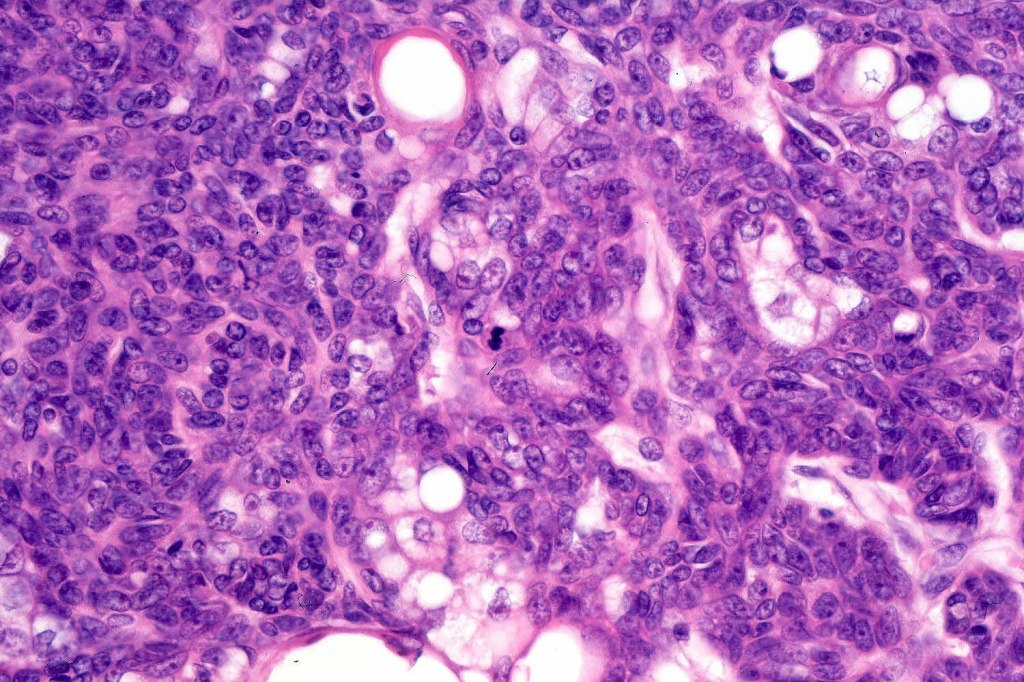

Sebaceous hyperplasia
Clinical features
•This is common and presents as single or commonly multiple, yellow dome-shaped umbilicated papule(s) (1-2 mm diameter) on face of the elderly but may occur on the chest, the caruncle, external genitalia & areola
•M>F
•Increased incidence with cyclosporine


Histological features
•Lobules drain into a dilated follicle
•Lobules are increased in number but do not differ in structures from normal sebaceous glands
•Sebaceous hyperplasia is not associated with Muir-Torre syndrome


Sebaceous adenoma
Clinical features
•Rare
•Presents as a pink/red to yellow papule/nodule most often on the face of elderly patients up to 0.5 cm diameter
•Can present on the medial canthus
•Associated with Muir-Torre syndrome
•Rare develops in a salivary gland
•May be found at the base of a keratin horn

Histological features
•Variable origin from epidermis
•Typically multilobulated, occasioanlly cystic
•Collagenous pseudocapsule
•At the periphery, single or multiple germinative cell layers maturing into typical sebaceous cells (>50%)
•Variable peripheral palisading
•+/- basal mitoses (particularly in the so-called giant variant which should not be misdiagnosed as sebaceous carcinoma)











Sebaceoma
Clinical features
•Usually single
•Flesh colored to yellow papule or nodule 1-3 cm diameter on the face or scalp
•29-87 years, most 6-9th decade
•Associated with Muir-Torre syndrome
•May develop in nevus sebaceus & in the ocular adnexa

Histological features
•Variable continuity with epidermis
•Multinodular with surrounding collagenous stroma
•Random distribution of basaloid cells & sebocytes (<50% sebocytes)
•Duct formation, often with holocrine secretion generally present
•Mitoses sparse to conspicuous
•Absent peripheral palisading & retraction artifact
•Cystic variant
•Subtypes include rippled pattern, carcinoid-like & reticulated
. Exceptionally, sebaceous carcinoma may arise from a sebaceoma
. Exceptionally, sebaceoma has been described with a seborrheic keratosis
. CAM5.2, keratin 14, adipophilin, EMA +ve, BerEP4 negative (compare with BCC- EMA -ve, BEREP4 +ve)

Sebaceous epithelioma
This poorly deineated term was used in the older literature. It included a variety of tumors including basal cell carcinoma with sebaceous differentiation, sebaceoma & some cases of sebaceous adenoma. It should not be used.
Leave a comment